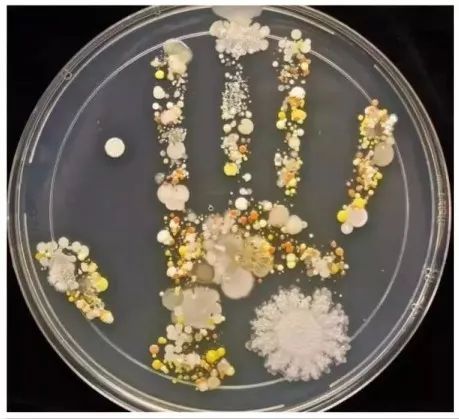

避免踩雷,四招破解冬季交叉感染难题!
2019年12月27日


老母亲总忧虑,冬季太难挨了。
冬季的确是流感以及其它各类传染病的高发季节。

去医院反而交叉感染了其他疾病
,加重了病情。
最有效的手段
,疫苗是流感防控最经济、有效的干预措施,优先推荐高危人群接种。

——白细胞吞噬能力依赖于血浆中的维生素C含量,维生素C也可以通过抗氧化作用促进抗体形成。[1]
6万中国医生推荐
的童年时光甜橙王子推荐给你!


两个多月没感冒了
”)

喝了VC很快就好了
)

很少生病吃药
)
新鲜萃取
VC 胜过食补 !

好喝就是力量
!

不失活
!



13阅读
3赞
inne官方海外旗舰店
已同步到看一看
写下你的想法